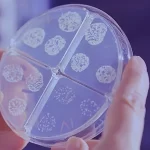
bacteria in water at microscope

How to Protect Your Family from Arsenic in Drinking Water
- Published:
- Updated: December 16, 2024
Summary
Ensuring safe drinking water is crucial for family health. Arsenic, a harmful contaminant, often goes unnoticed due to its odorless and tasteless nature. Here’s how to safeguard your family:
- Identify Arsenic Sources: Understand how arsenic enters drinking water to mitigate exposure risks.
- Test Your Water: Regularly test your water for arsenic presence, either through professional labs or home-based kits.
- Employ Arsenic-Reducing Technologies: Consider using water filters, reverse osmosis, or distillation to lower arsenic levels.
If we are trying to offer a healthy and safe place to our families and friends, it is often water. Arsenic is one of the smallest but perhaps most dangerous contaminants in our water. Arsenic is a semi-metallic element in the Earth’s crust. It happens naturally, but humans can bring some (mineralising, spraying pesticides, and so on) into the mix to help it get in our world. There are two types of arsenic: organic and inorganic – the latter being the more toxic, which is found most commonly in groundwater.
Chronic health effects can occur when you get exposed to inorganic arsenic. It has been connected to all types of cancers, heart disease, brain disease, diabetes, and even skin conditions. Babies, children, pregnant women and patients with an ailing immune system are especially vulnerable.
How does arsenic find its way into drinking water?
Arsenic gets into drinking water through many routes. Arsenic also escapes into the groundwater from nearby rocks and soils, of course. Arsenic can enter our water supplies from the industrial processes, from arsenic-based pesticides and from unrecognised waste disposal, as well.
The geographical location also matters a lot when it comes to arsenic pollution. Some places have higher natural arsenic concentrations in the soil, and thus, more threat of contaminated groundwater. Having an idea if you’re located in a risk region can be one of the most important decisions you can make to protect your family’s health.
Detecting Arsenic in Your Drinking Water
Because arsenic is colorless, tasteless and odorless, regular testing is the only sure-fire way to know if you have it in your water. Water testing for arsenic can be carried out at many labs. They typically require you to send in a water sample and the result is reviewed and returned.
There are also home arsenic test kits for quick or regular tests. They are not as reliable as professional lab analysis, but they are quick and relatively inexpensive way to check arsenic levels.
The Legal Limits and Recommendations for Arsenic in Water
Regulatory agencies worldwide have set limits on acceptable levels of arsenic in drinking water. The U.S. Environmental Protection Agency (EPA), for instance, has set the Maximum Contaminant Level (MCL) for arsenic at 10 parts per billion (ppb). However, no level of arsenic is considered entirely safe, and experts recommend aiming for as low as reasonably achievable.
The World Health Organization also suggests a limit of 10 ppb. It’s important to understand that these standards are set based on a balance of risk, technological feasibility, and cost, rather than a guarantee of safety.

Arsenic-Reducing Technologies for Home Use
Thankfully, several technologies can help reduce arsenic levels in drinking water. These include:
- Water Filters: Certain water filters, especially those using activated alumina or enhanced filtration, can effectively remove arsenic.
- Reverse Osmosis: This process can remove up to 95% of arsenic from water.
- Distillation: While energy-intensive, distillation can be a highly effective way of removing arsenic.
Bear in mind, not all water filtration methods are effective against arsenic, so be sure to choose a system certified for arsenic removal.
Arsenic in Bottled Water and Alternatives
Arsenic won’t necessarily be out of the question if you drink water from a bottle. Some brands even had suspicious levels of arsenic. But a lot of brands follow strict purification protocols and the stuff they sell is safe. Before you buy bottled water, research the source of water and the purification system of the brand.
There are other options too. You can consider water delivery services especially reverse osmosis distilled water. There are water stations at some grocery stores, too, so you can use your own tubs to re-fill them with filtered, bottled water.
Dealing with Arsenic Contamination in Wells
For arsenic contamination in your well water, it’s more complicated. An arsenic-control solution is to drill down deeper, since arsenic contamination tends to be more concentrated in the lower levels of groundwater. Depending on which depth or layer in your well is suspected to contain high arsenic levels, it can be sealed so the rest of the well doesn’t get contaminated.
And you can even put a treatment plant directly on your well. It could be a point-of-entry system that cleans every drop of water coming into your home or a point-of-use system, installed at one faucet, that cleans just the water you use for drinking and cooking.
Community Action and Policy Change for Arsenic-Free Water
Individuals have a very important role to play, but together, everyone matters. Start by getting your local community educated about arsenic pollution. Demand regular city water testing and tougher enforcement of regulation.
A municipal water treatment system may be possible in some instances. These might be centralised arsenic removal systems, which purify water at the source before delivering it.
There also needs to be political change on arsenic pollution. Protesting for higher arsenic standards and regulations, increasing compliance with current policies, and more investment in the research and development of arsenic-removing technologies can all lead to safer water for all.
Share this on social media: